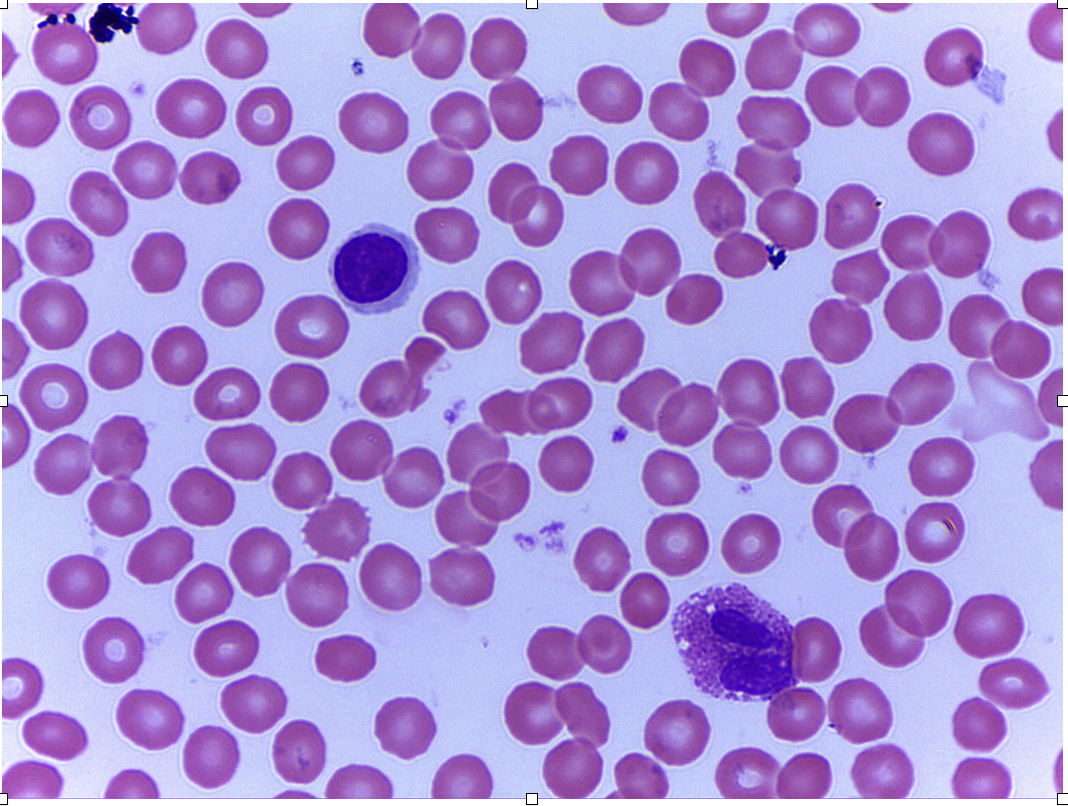

1/268
Looks like no tags are added yet.
Name | Mastery | Learn | Test | Matching | Spaced | Call with Kai |
|---|
No analytics yet
Send a link to your students to track their progress
Prophase

Metaphase

Anaphase

Telophase

Mitotic Spindle
Sebaceous Gland

Arrector Pili Muscle

Hair shaft

Sweat pore

Hair follicle

Hair root

Eccrine Sweat Gland

Hair Papilla

Apocrine Sweat Gland

Pacinian Corpuscle

Areolar CT

Adipose Tissue

Hyaline Cartilage

Compact Bone

Dense Regular CT

Dense Irregular CT

Blood
Skeletal Muscle

Cardiac Muscle

Smooth Muscle

Simple Squamous Epithelium

Simple Cuboidal Epithelium

Simple columnar epithelium

Pseudostratified Columnar Epithelium

Stratified Squamous Epithelium

Transitional Epithelium

Nervous Tissue

Epiphysis

Diaphysis

Spongy bone

Compact bone

Endosteum
Periosteum

Medullary Cavity

Marrow

Perforating (sharpey’s) fibers

Osteon

Lacune (hole that holds an osteocyte)

Canaliculi (tiny lines)

Circumferential Lamellae

Concentric Lamellae (layers of circles within osteons)

Interstitial Lamellae (incomplete arcs between osteons)

Central Canal

Perforating Canal

Nutrient Arteries

Cranium (brain case)

Facial bones

Cranial Vault

Cranial Floor

Anterior Cranial Fossa

Middle Cranial Fossa

Posterior Cranial Fossa

Frontal Bone

Supraorbital Foramen

Glabella

Parietal Bone

Sagittal Suture

Coronal Suture

Squamous Suture

Lambdoid Suture

Temporal Bone

Zygomatic Process

Mandibular fossa (of temporal bone)

External Acoustic Meatus

Styloid Process

Mastoid Process

Stylomastoid Foramen

Jugular foramen

Carotid canal

Internal acoustic meatus

Foramen lacerum

Occipital bone

Foramen magnum

Occipital condyles
Hypoglossal canal

External occipital crest

Greater wings

Lesser wings

Superior orbital fissure

Inferior orbital fissure

Sella turcica

Optic Canal

Foramen rotundum

Foramen ovale

Crista galli (sticks up)

Cribriform Plate (flat)

Olfactory foramina (holes)

Perpendicular plate

Lateral Masses

Middle nasal concha

Inferior nasal concha

Mandible

Mandibular ramus

Mandibular angle

Mandibular condyle
